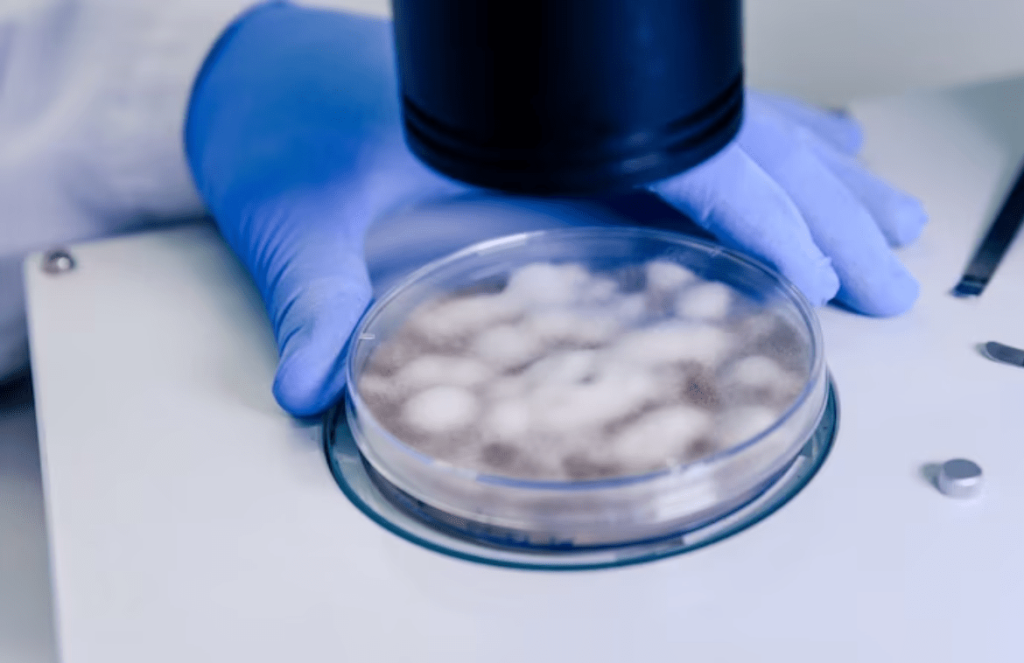
Expectations of Microscopic Treatment for Male Infertility

Microscopic treatment is adhered to when diagnosing male infertility and its aftermath treatment processes. Male infertility is of much concern to health experts as often it is the cause of not being able to bear a child by couples.
Microscopic treatment for male infertility happens to be a specialized surgical procedure that has indeed revolutionized the treatment options for men with severely impaired sperm production or no sperm in their ejaculate. It does offer a microscopic solution to male infertility by providing a targeted approach to sperm retrieval. The procedure is indeed known as Microscopic Testicular Sperm Extraction (MicroTESE).
Infertility does affect 10–15% of couples, thus making it one of the most frequent health disorders for individuals of reproductive age. The state of childlessness and also the efforts made to restore fertility do cause substantial emotional, social, as well as financial stress on the couples. Male factors do contribute to about half of all infertility cases and yet are understudied relative to female factors. The result of course is that the majority of men with infertility lack specific causal diagnoses, which does serve as a missed opportunity to inform therapies for such couples.
Failure to conceive within 12 months of attempted conception is on account of whole or in part to the male responsibility in approximately one-half of all infertile couples. Although several couples can indeed achieve a pregnancy with assisted reproductive technologies (ART), evaluation of the male is rather important to most appropriately direct therapy. Few male factor conditions are treatable with medical or surgical therapy, and others may only rather be managed with donor sperm or adoption. Certain conditions are life-threatening, while others tend to have health as well as genetic implications for the patient and also potential offspring. Without the assistance of a male evaluation, it is not possible to adequately design the management of the patient and the couple.
What more about the Microscopic Treatment of Male Infertility?
- Clinicians need to obtain hormonal evaluation including follicle-stimulating hormone (FSH) and testosterone for infertile men with impaired libido, erectile dysfunction, oligozoospermia or azoospermia, atrophic testes, or perhaps evidence of hormonal abnormality on physical evaluation.
- Azoospermic men need to be initially evaluated with semen volume, physical exam, as well as FSH levels to differentiate genital tract obstruction from impaired sperm production.
- Karyotype and Y-chromosome microdeletion analysis need to be recommended for men with primary infertility and azoospermia or even severe Oligozoospermia with elevated FSH or testicular atrophy or perhaps a presumed diagnosis of impaired sperm production as the cause of azoospermia.
- Clinicians need to recommend Cystic Fibrosis Transmembrane Conductance Regulator (CFTR) mutation carrier testing (including assessment of the 5T allele) in men with vasal agenesis or idiopathic obstructive azoospermia.
- For men who do harbor a CFTR mutation, genetic evaluation of the female partner needs to be recommended.
- Sperm DNA fragmentation analysis is not recommended in the initial evaluation of the infertile couple.
- Men with increased round cells on SA (>1 million/mL) should be evaluated further to differentiate white blood cells (Pyospermia) from germ cells.
- Patients with Pyospermia of course need to be evaluated for the presence of infection.
- Antisperm antibody (ASA) testing obviously should not be done in the initial evaluation of male infertility.
- For couples with RPL, the men have to be evaluated with karyotype and sperm DNA fragmentation.
- Diagnostic testicular biopsy should not be performed routinely to differentiate between obstructive azoospermia as well as non-obstructive azoospermia (NOA).
Therapeutic interventions are rather presented in detail, mainly in the areas of sperm retrieval, varicocele repair, and also intra-cytoplasmic sperm injection that includes potential complications as well as extreme challenges as complete failed fertilization. Various approaches to fertility preservation are there, including advances in prepubertal fertility preservation.

No need to worry, your data is 100% safe with us!
No need to worry, your data is 100% safe with us!